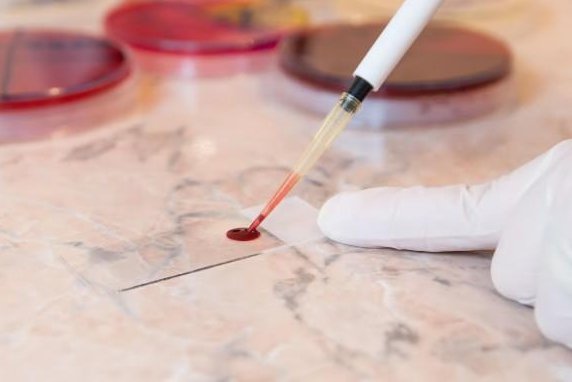
Rapid blood test can hasten treatment for stroke patients with brain bleeding Rapid blood test can hasten treatment for stroke patients with brain bleeding

Rapid blood test can hasten treatment for stroke patients with brain bleeding

A blood test that detects GFAP during emergency transport could kick off effective treatment for these patients before they even get to the hospital, potentially reducing their brain damage from stroke, researchers said. Adobe stock/HealthDay
A rapid blood test could speed treatment for people who have suffered a stroke related to brain bleeding, a new study says.
Stroke victims with brain bleeds have nearly seven times higher blood levels of a brain protein called glial fibrillary acidic protein, or GFAP, compared to patients with strokes caused by a blood clot, researchers found.
A blood test that detects GFAP during emergency transport could kick off effective treatment for these patients before they even get to the hospital, potentially reducing their brain damage from stroke, researchers said Thursday ahead of the American Stroke Association’s annual meeting in Los Angeles next week.
“It is crucial to differentiate these two types of stroke because they need opposite treatments,” lead researcher Dr. Love-Preet Kalra, a neurology resident at the RKH Hospital Klinikum Ludwigsburg in Germany, said in an ASA news release.
“In ischemic stroke, you need to open the blocked blood vessel with clot-busting drugs or physically remove the clot,” Kalra added. “In contrast, in a bleeding stroke, you need to lower increased blood pressure and give medication to reverse the effects of certain blood-thinning drugs.”
The more time that elapses before a stroke is diagnosed and treated, the more brain tissue is irreparably damaged, researchers said in background notes.
Currently, doctors use imaging scans to distinguish between bleed-based versus clot-caused strokes, researchers said.
Unfortunately, those scans can be delayed for hours while a patient is being stabilized, evaluated in the emergency room and then sent on to radiology, researchers noted. All the while, brain cells are dying.
The research team figured that GFAP might be useful in detecting a brain-bleed stroke. The protein is released into the bloodstream when brain cells are damaged and destroyed, and it’s already used when assessing traumatic brain injuries.
The study involved 353 patients treated within six hours of the onset of stroke symptoms.
Blood samples were taken on the way to the emergency room and tested for GFAP levels using a portable blood analyzer.
Brain imaging at the hospital revealed that bleeding strokes had occurred in 76 people, clot-caused strokes in 258 people, and conditions that mimic stroke like seizures or migraine in 19 people.
GFAP levels were nearly seven times higher in bleeding stroke patients compared to those with clot-caused strokes, and more than four times higher in people with a bleeding stroke than a stroke-mimicking condition, results show.
Researchers were able to predict which patients had a bleeding stroke with up to 95% accuracy when age was taken into account, according to their presentation.
In addition, GFAP levels were higher in bleeding stroke patients who were taking blood thinners.
If these results are confirmed in larger studies, the blood test could revolutionize treatment of stroke, Kalra said.
“Treatment to lower blood pressure and reverse blood-thinning medications could be performed in the prehospital setting, leading to a huge change in clinical practice,” Kalra said. “In the future, even blood thinners or clot-busting treatment might be applied before people reach the hospital.”
American Heart Association volunteer Dr. Louise McCullough agreed that the study results need to be verified in studies involving more people.
“The study had a relatively small sample size, and for the test to be effective, both the patient’s blood and the GFAP test must be available as a “point of care” test in the field,” McCullough, chief of neurology at Memorial Hermann Hospital-Texas Medical Center in Houston, said in a news release.
“Currently, most ambulances and emergency medical services do not have access to this blood test,” McCullough pointed out, who was not involved in the study.
Findings presented at medical meetings should be considered preliminary until published in a peer-reviewed journal.
The U.S. Centers for Disease Control and Prevention has more about stroke.
